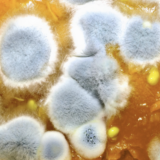

5 Eat Better Tips You Can Do NOW With Minimal Effort
Check out my 5 Eat Better Tips you can do NOW With Minimal Effort: 1. Plan your meals Create a weekly meal plan, including a variety of nutritious foods, to | More

Check out my 5 Eat Better Tips you can do NOW With Minimal Effort: 1. Plan your meals Create a weekly meal plan, including a variety of nutritious foods, to | More

As a raw food health coach, I encounter countless individuals grappling with embracing healthier eating habits. Even if they are in some level of pain around it, ie. struggling with | More

What is Resistant Starch and Butryic Acid and how does it help with good gut health? Resistant starch is a type of starch that doesn’t break down. It “resists” digestion | More
This is a common concern when people are new to fermenting foods at home, and they spot mold on their ferment. Especially when mold can be associated with allergies and | More

In this blog, find out the 3 reasons why fermented foods will help you through any food shortage. With recent global events, many of us are concerned about food shortages, | More

For years, we’ve been told that beauty comes from within. But what does that really mean? It turns out, there’s a lot of truth to that saying – especially when | More

Please check your spam folder if you do not see our emails in your inbox. Make sure to whitelist our email address so you always get all our juicy updates and free material.

